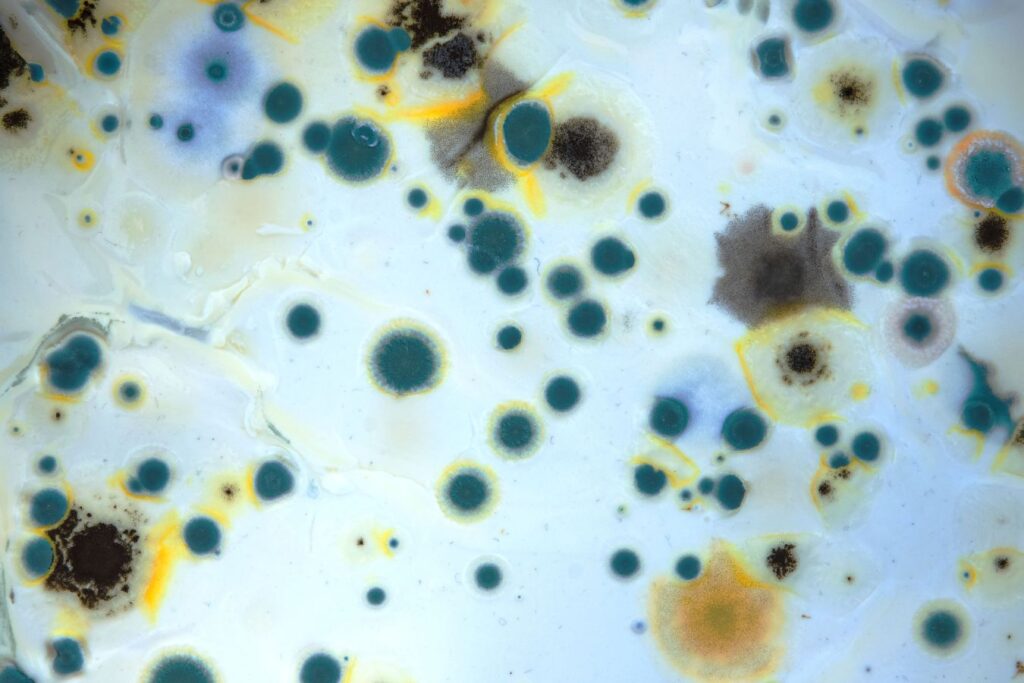

Eddig is tudtuk, hogy a penészgomba-toxinok számos negatív egészségügyi hatással járhatnak, attól függően, hogy milyen típusú toxinnal van dolgunk és milyen mértékben kerül az a szervezetbe. Ezek a toxinok gyulladáskeltő hatástól kezdve a veseproblémákon át az immunrendszer gyengítéséig terjedő káros hatásokkal rendelkeznek. Az ösztrogénszerű mikotoxinok, mint a Zearalenon, a hormonrendszer zavarát okozhatják, míg más vegyületek, mint az ochratoxin A, a veséket károsítják. Ezen túl a neurotoxikus mikotoxinok a kognitív funkciókra is negatív hatást gyakorolhatnak.
Bizonyos gombatoxinok rákot is okozathat. Ilyen például az aflatoxin, ami bizonyítottan májdaganatot okozhat.
Most azonban a Semmelweis Egyetem és a Magyar Agrár- és Élettudományi Egyetem (MATE) közös kutatása1 egy még kevéssé ismert területre hívta fel a figyelmet: a penészgombák által termelt toxinok hatására a női termékenység és a mesterséges megtermékenyítés sikerének összefüggésében.

A mikotoxinok és a termékenység kapcsolata
A Semmelweis Egyetem és a MATE közös kutatása2, amely a világon elsőként mutatta ki penészgombák által termelt toxinok jelenlétét az emberi tüsszőfolyadékban, alapvető kérdéseket vet fel a meddőség eddig kevéssé ismert okairól. A kutatás során huszonöt lombikprogramban részt vevő páciens tüsszőfolyadék- és vérmintáit elemezték, hogy megértsék, milyen módon kerülnek ezek a toxinok a szervezetbe, és milyen mértékben befolyásolják a termékenységet.
„Eredményeink alapján valószínűsíthető, hogy a follikuláris folyadékban jelen lévő gombatoxinok befolyásolják egyes hormonok működését, a petesejtek minőségét, életképességét, és így a megtermékenyülést” – mondta dr. Szentirmay Apolka, a Semmelweis Egyetem Szülészeti és Nőgyógyászati Klinikájának szakorvosa.
A kutatás eredményei
A vizsgálat során valamennyi vizsgált toxin kimutatható volt a tüsszőfolyadékban, még akkor is, ha a vérben csak alacsonyabb koncentrációban vagy egyáltalán nem volt jelen. Ez arra utal, hogy
a toxinok felhalmozódhatnak a follikuláris folyadékban, ahol befolyásolhatják a petesejtek minőségét, életképességét, valamint a hormonok működését.
Különösen aggasztó a Zearalenon nevű toxin jelenléte, amely kukoricában és gabonafélékben fordul elő.
Ez a toxin ugyanis az ösztrogén receptorokhoz kötődve csökkentheti az érett, megtermékenyíthető petesejtek számát, valamint hozzájárulhat az embrió fejlődésének megzavarásához.
Az eredmények alapján feltételezhető, hogy a Zearalenon és az ösztrogén receptorok kölcsönhatása erősíti a toxin negatív hatásait.
Ugyanakkor a kutatók megfigyeltek egy pozitív hatású mikotoxint is. A Fusarium penészgomba által termelt Fumonisin B1 kis koncentrációban növelte a tüsszősejtek és a kinyert petesejtek arányát.
„Lehetséges, hogy valamilyen védőfunkcióval bír; a mindennapokban is ismerünk penészgomba származékot, melyet gyógyszerként szedünk, ilyen például a penicillin” – magyarázza dr. Sára Levente, a Semmelweis Egyetem Szülészeti és Nőgyógyászati Klinikájának adjunktusa.
Mi a helyzet a lakásban található penészgombákkal?
Nemcsak az élelmiszerekben található mikotoxinok okozhatnak problémát, hanem a lakásokban, házakban előforduló penészgombák3 is kockázatot jelenthetnek. A levegőben terjedő penész spórák belégzése és a velük való folyamatos érintkezés ugyanis többek között allergiás reakciókat, gyulladásokat és oxidatív stresszt okozhat. Ezek a folyamatok nemcsak az általános egészségi állapotra, hanem a hormonrendszerre is negatív hatással lehetnek.

Mit tehetünk?
Dr. Sára Levente, a Semmelweis Egyetem adjunktusa szerint a kutatás eredményei kiemelik, hogy a mikotoxinok élelmiszerláncban való jelenlétét szigorúan ellenőrizni kellene.
„Tanulmányunk rámutat, milyen szerepet játszanak a környezeti tényezők a meddőség kialakulásában. További kutatásokkal kiegészítve eredményeink segíthetnek feltárni a meddőség egyes okait és megérteni, pontosan hogyan hatnak a gombatoxinok a női termékenységre” – mondja dr. Sára Levente kiemelve, a kockázatok csökkentése érdekében a gombatoxin-szennyezés szorosabb nyomon követése szükséges az élelmiszerláncban.
Az ellenőrzés és a nyomonkövetés nemcsak az élelmiszerbiztonság, hanem a termékenység védelme szempontjából is kiemelkedő fontosságú lenne.
Ugyanilyen fontos a lakások megfelelő szellőztetése és a penészt okozó nedvesség megszüntetése, hogy csökkentsük a lakásokban található penészgombák által okozott kockázatokat.
Vigyázz az egészségedre, és a tested jelzéseire.
